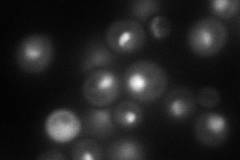
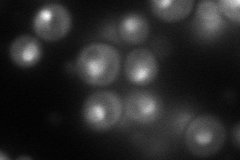

View description
Possible U3 snoRNP protein involved in maturation of pre-18S rRNA, based on computational analysis of large-scale protein-protein interaction data
Localization:
Intensity:
Fold change:
Significance:
-
C’ GFP library in SD

nucleolus68.4 -
N' NOP1pr-GFP in SD
nucleolus97.5299 -
N' TEF2pr-mCherry in SD
nucleus,nucleolus105.904 -
N' NATIVEpr-GFP in SD

nucleolus50.4851 -
N' TEF2pr-VC and Cyto-VN in SD

nucleus,nucleolus50.4596 -
C’ GFP library in SD+DTT

nucleolus57.670.84No -
C’ GFP library in SD+H2O2

nucleolus77.451.13No -
C’ GFP library in Starvation Media

nucleolus44.120.64No -
C’ GFP library on the background of Pup2-DaMP

nucleolus -
C’ GFP library on the background of CCT mutant

nucleolus95.50431.3961Yes
